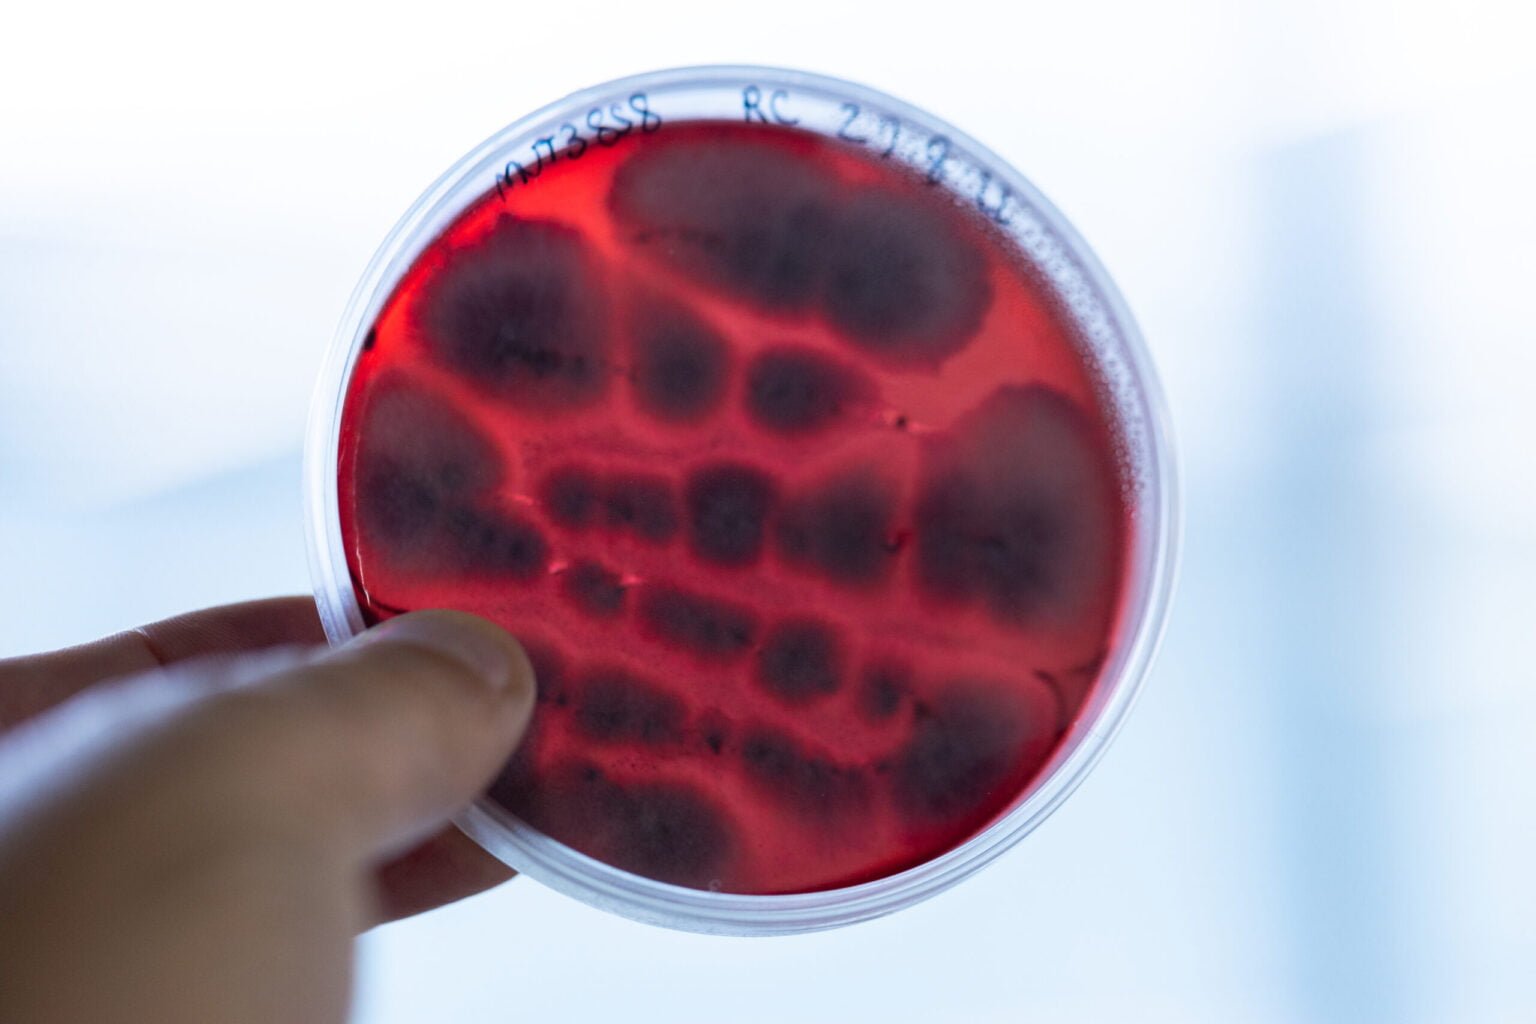

BioTopics22
Circulating Ideas
28 September 2022
Kilometro Rosso Spazio Eventi - Via Stezzano 87, Bergamo, Italy

About the Event
Second Edition focused on the #BioTopics of Bioeconomy, Circular Economy, Sustainability and Biotechnology.
The event organised by BGreen Technologies brought together professionals, companies and universities to address the topics of sustainability, green economy and biotechnology.
Seven speeches in the morning session, the presentation of BGreen Solutions and the Finals of the Sustainability Challenge promoted by Lamiflex SPA and sponsored by Biotecnologi Italiani in the afternoon session.
Event Schedule
The day is divided into two sessions: speeches will be given in a conference format during the morning, while the afternoon session will be entirely dedicated to the BGT Solutions presentation and Challenge finals!
10:00 AM
Registration & Welcome Coffee
Spazio Eventi Kilometro Rosso
10:30 AM
Introduction & Opening
Speaker: Davide Ederle
10:40 AM
From Euglena to
Eglix project
Speaker: Prof.ssa Valeria Mezzanotte
11:00 AM
Innovability in Textile sector
Speaker: Giorgia Carissimi
11:20 AM
Wood in the Decorative Surfaces Industry
Speaker: Marco Lelli
11:40 AM
Lamiflex:
innovation in composites
Speaker: Massimo Zocche
11:55 AM
New Life for Plastic, the Plasta Rei
Project
Speaker: Fabio Mazzarella
12:10 PM
BGreen:
results &
perspective
Speaker: Raffaele Cavaliere
12:30 PM
Lunch Time & Networking
Piazza delle Idee
02:00 PM
BGT Solutions Presentation
Speaker: Alvise Baratella
02:30 PM
Challenge Finals & Awards
03:45 PM
Conclusion & Next Steps
Speaker: BGT Team
Meet the Speakers
Our bench of speakers is multi-disciplinary and includes some well-established and successful professionists, who will guide us through several key aspects of the ecological transition. Join the event and take a step closer to being an expert.
Join Us!
Gallery
Sponsors & Partners
We warmly thank all our Partners for helping us to make this second edition of BioTopics truly special!